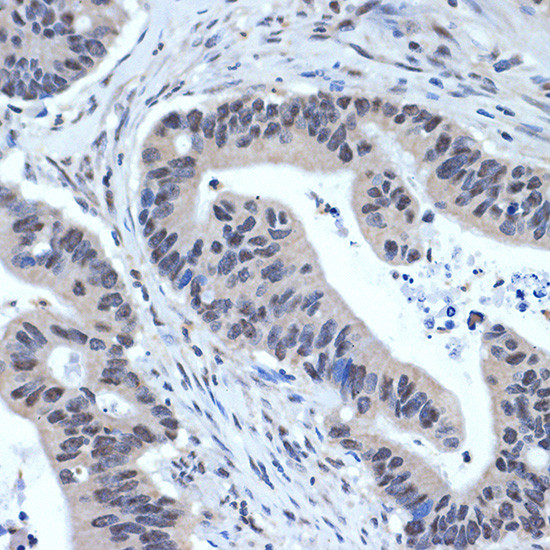
XPD Antibody in Immunohistochemistry (Paraffin) (IHC (P))

Search
Invitrogen
XPD Recombinant Rabbit Monoclonal Antibody (6T9K6)
{{$productOrderCtrl.translations['antibody.pdp.commerceCard.promotion.promotions']}}
{{$productOrderCtrl.translations['antibody.pdp.commerceCard.promotion.viewpromo']}}
{{$productOrderCtrl.translations['antibody.pdp.commerceCard.promotion.promocode']}}: {{promo.promoCode}} {{promo.promoTitle}} {{promo.promoDescription}}. {{$productOrderCtrl.translations['antibody.pdp.commerceCard.promotion.learnmore']}}
图: 1 / 4
XPD Antibody (MA5-37877) in IHC (P)




Please note: We are reviewing Western blot images included in the antibody testing data in our catalog, including those provided by third parties. Unless expressly labeled or annotated as “raw-unedited”, Western blot images included in the antibody testing data in our catalog may have been edited, optimized or otherwise adjusted for presentation.
产品信息
MA5-37877
种属反应
宿主/亚型
Expression System
分类
类型
克隆号
抗原
偶联物
形式
浓度
规格
纯化类型
保存液
内含物
保存条件
运输条件
RRID
产品详细信息
Positive Samples: HeLa, 293T, A-549
Immunogen sequence: ARGKVSEGID FVHHYGRAVI MFGVPYVYTQ SRILKARLEY LRDQFQIREN DFLTFDAMRH AAQCVGRAIR GKTDYGLMVF ADKRFARGDK RGKLPRWIQE H
靶标信息
XPD is involved with the nucleotide excision repair pathway that is a mechanism to repair damage to DNA. The protein encoded by this gene is involved in transcription-coupled nucleotide excision repair and is an integral member of the basal transcription factor BTF2/TFIIH complex. The gene product has ATP-dependent DNA helicase activity and belongs to the RAD3/XPD subfamily of helicases. Defects in this gene can result in three different disorders, the cancer-prone syndrome xeroderma pigmentosum complementation group D, trichothiodystrophy, and Cockayne syndrome. Alternatively spliced transcript variants encoding different isoforms have been found for this gene.
仅用于科研。不用于诊断过程。未经明确授权不得转售。
篇参考文献 (0)
生物信息学
蛋白别名: Basic transcription factor 2 80 kDa subunit; BTF2 p80; CXPD; DNA 5'-3' helicase XPD; DNA excision repair protein ERCC-2; DNA repair protein complementing XP-D cells; excision repair cross-complementing rodent repair deficiency, complementation group 2; General transcription and DNA repair factor IIH helicase subunit XPD; MGC102762; MGC126218; MGC126219; TFIIH 80 kDa subunit; TFIIH basal transcription factor complex 80 kDa subunit; TFIIH basal transcription factor complex helicase subunit; TFIIH basal transcription factor complex helicase XPD subunit; TFIIH subunit XPD; Xeroderma pigmentosum group D-complementing protein
基因别名: AA407812; AU020867; AW240756; CXPD; Ercc-2; ERCC2; XPD; XPDC
UniProt ID: (Mouse) O08811
Entrez Gene ID: (Mouse) 13871, (Rat) 308415